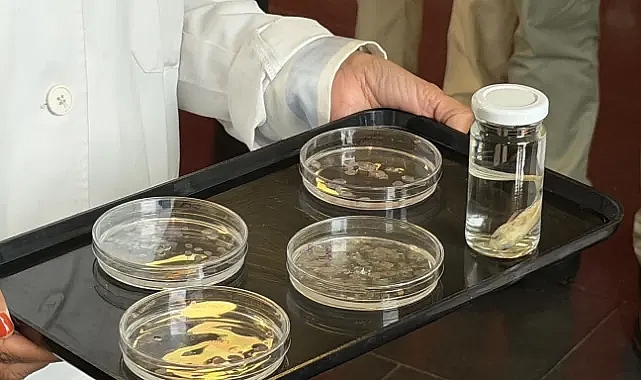
Balık pulları kornea bağışçısı sıkıntısına çözüm olabilir

denge sende


Geleceğin Yeşil İş Dünyası İçin Önemli Buluşma: "Future of Green Business" Etkinliği
Geleceğin Yeşil İş Dünyası İçin Önemli Buluşma: "Future of Green Business" Etkinliği

Sürdürülebilirlik öykünüzü anlatırken tepkileri nasıl önleyebilirsiniz?
Sürdürülebilirlik öykünüzü anlatırken tepkileri nasıl önleyebilirsiniz?

İşletmeler neden ağaç dikmeyi bırakıp ormanları korumaya başlamalı?
İşletmeler neden ağaç dikmeyi bırakıp ormanları korumaya başlamalı?

8 Mart Dünya Kadınlar Günü'nü Sevgili Ekosistem Partnerimiz Assembly Buildings 'in eşsiz ofisinde TurkishWIN Hikaye Hasadı Etkinliği ile kutlandı!
8 Mart Dünya Kadınlar Günü’nü Sevgili Ekosistem Partnerimiz Assembly Buildings ’in eşsiz ofisinde TurkishWIN Hikaye...

AB parlamento ve üye ülkeler hava kirliliği konusunda anlaşmaya vardı
AB parlamento ve üye ülkeler hava kirliliği konusunda anlaşmaya vardı

AB Politikası. Burger ambalajlayıcıları ambalaj atıklarına yönelik kısıtlamalardan sağ kurtuldu
AB Politikası. Burger ambalajlayıcıları ambalaj atıklarına yönelik kısıtlamalardan sağ kurtuldu